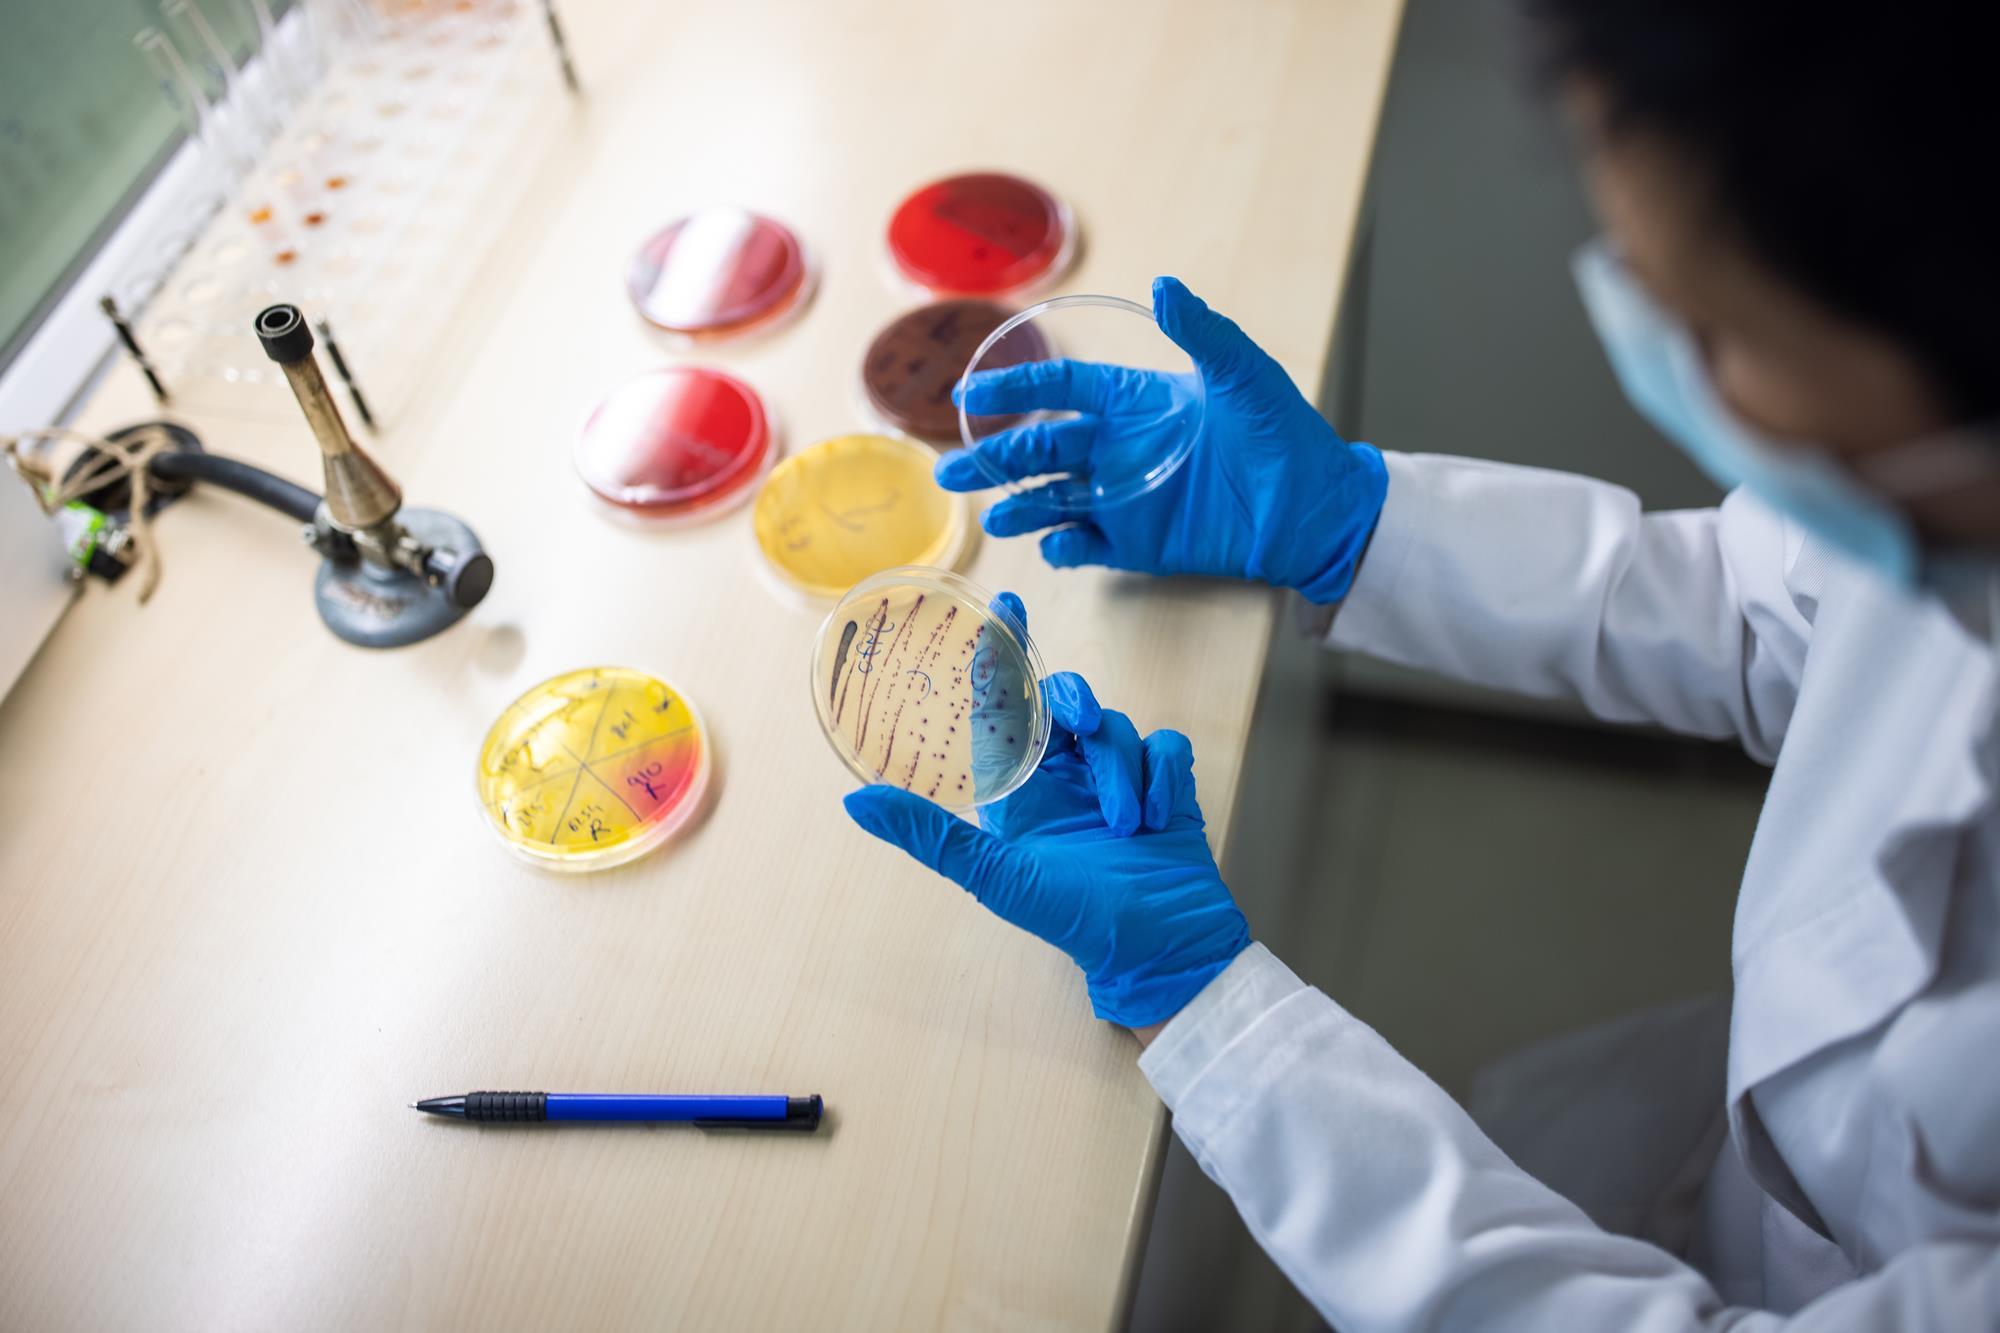
Antibacterial Research

Biomaterials Development
Design and synthesis of novel biomaterials for tissue regeneration, drug delivery, and medical devices.
Advanced Bioengineering Research and Development Laboratory
To advance the field of bioengineering through innovative research, cutting-edge technology, and collaborative partnerships that address critical healthcare challenges and improve patient outcomes.
To be a world-leading bioengineering research laboratory that transforms scientific discovery into practical solutions for global health challenges, while training the next generation of bioengineering leaders.
Advanced Equipment
Research Publications
Services Offered
Active Projects
Exploring cutting-edge research domains in bioengineering

Design and synthesis of novel biomaterials for tissue regeneration, drug delivery, and medical devices.

Development of functional tissues and organs using stem cells, scaffolds, and bioreactors.

Advanced spectroscopic analysis for material characterization and biological interactions.
Development and testing of novel antibacterial materials and coatings.
Meet our dedicated researchers and staff

Chief Executive Officer
My research interests focus on biomaterials, tissue engineering, and protein engineering for biomedical applications. I work on orthopedic and dental biomaterials, soft tissue engineering, wound healing, magnetic drug therapy, and targeted drug delivery systems. A major part of my research involves developing novel proteins for tissue engineering, including protein-functionalized coatings for implants, protein nanoparticles for drug delivery, and 3D-printed protein-based skin patches. I am particularly interested in electrophoretic deposition of complex proteins and bioactive nanostructured coatings, as well as 3D-printed and electrospun scaffolds incorporating bioactive glass and therapeutic ions to enhance regeneration and antibacterial performance.

Managing Director
My research interests focus on the intersection of biofabrication and regenerative medicine, specifically the development of patient-specific 3D-printed scaffolds and bio-inks (e.g., alginate, guar gum, and PEEK) for complex skin regeneration, burn care, and cartilage repair. I specialize in engineering multifunctional surface coatings and hydrogels that incorporate therapeutic ions, exosomes, and natural bioactive agents to provide sustained antimicrobial efficacy and enhanced osseointegration for orthopedic implants. Furthermore, I am dedicated to advancing translational research through comprehensive biological profiling, including in-vivo mice models and CAM assays, to validate the angiogenic and healing potential of innovative biomaterials for clinical applications.

Chief Technical Officer
My research interests focus on biomaterials, bioactive coatings, and surface engineering for biomedical applications. I primarily work on electrophoretic deposition (EPD) of polymer and biopolymer-based composite coatings, incorporating natural herbs, metallic ions, and bioactive glass nanoparticles for orthopedic and dental implants. My interests also include corrosion and tribological behavior of implant coatings, wear resistance, and antibacterial performance of functionalized surfaces. I am actively involved in developing PEEK based composite coatings, chitosan-based systems, and herb-loaded bioactive coatings to improve implant longevity and biological response.

Research Assistant
My current research interests lie in development of Polyether ether ketone-based 3D printed bioactive scaffolds for bone and dental tissue engineering, Development of bioactive electrospun nanofibrous mats for cartilage tissue engineering, Anti-inflammatory ions loaded bioactive glass for MASH treatment and 3D bioprinted scaffolds for wound healing applications.

Research Assistant
My focus lies at the forefront of Biomedical Engineering and Material Science, specifically in the domain of Tissue Engineering. I am dedicated to the development and characterization of advanced biomaterials, including hydrogels, 3D printed scaffolds, and nanofibers. My work primarily aims to address challenges in wound repair, burn care, and drug delivery systems by utilizing novel biopolymer composites (such as alginate, chitosan, and guar gum) and reinforcing them with bioactive agents like mesoporous bioactive glass nanoparticles (MBGNs). I am particularly interested in the intersection of biological characterization and material fabrication to create biomimetic solutions that enhance cell proliferation and tissue regeneration.

Research Assistant
My research interests focus on biomaterials and tissue engineering for regenerative medicine, including both hard and soft-tissue applications. I work on polymer-based and polymer–ceramic composite systems for implant surface engineering, with emphasis on biocompatibility, tribocorrosion resistance, and antibacterial functionality. In parallel, I am interested in soft tissue engineering approaches, such as hydrogels and porous scaffolds, for wound healing and burn care management, aiming to enhance cellular response and tissue regeneration through controlled material design and surface modification .
Our commitment to excellence in bioengineering research
Conduct high-impact research that advances the field of bioengineering and contributes to scientific knowledge.
Develop innovative technologies and methodologies that enable new discoveries and applications.
Foster interdisciplinary collaborations with academic, clinical, and industrial partners.
Train the next generation of bioengineers through hands-on research experience and mentorship.
Join us in advancing bioengineering research and making a difference in healthcare innovation.